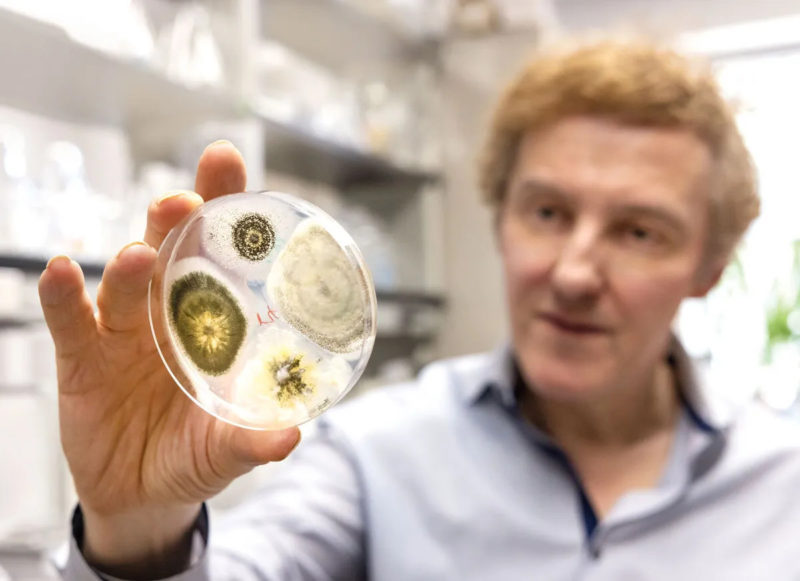
科學家改造黴菌成散發花香，引誘蚊子自投羅網

蚊子不只擾人,還會傳播多種致命疾病。面對氣候變遷導致病媒蚊擴散,傳統防治手段逐漸失效。最近美國馬里蘭大學(University of Maryland)開創新方向:讓蚊子「剋星」綠僵菌(Metarhizium fungus),散發強烈花香誘其落入致命陷阱。這項生物防治領域的重大突破,論文近日刊登於《自然微生物學》(Nature Microbiology)期刊。
綠僵菌(又稱黑僵菌)廣泛分布自然界土壤,能感染蚊子等多種昆蟲,導致宿主死亡。但綠僵菌被動等待蚊子接觸才有機會感染。團隊決定改造綠僵菌,讓它不只被動等待,還能主動引誘蚊子「自投羅網」。
雌蚊產卵前才需要吸血補充蛋白質,平時也會吃花蜜,故喜歡花香味。團隊運用基因工程改造綠僵菌,使之散發長葉烯(Longifolene)天然花香化合物。它對人類無害,卻對蚊子極具吸引力。
誘殺成功超過九成蚊子
當基改黴菌釋放長葉烯時,蚊子會誤以為附近有花蜜可採,主動靠近。接觸瞬間,孢子就會附著蚊子體表,再入侵體內。感染蚊子數日內就可能不堪病菌攻擊死亡。實驗顯示,即使同時有人類氣味與其他植物氣味環境,花香綠僵菌也能吸引超過九成蚊子靠近,數日內造成接近100%死亡率。
這項研究改變傳統「防蚊思維」,不再只是驅趕或毒殺,而巧妙利用蚊子天性反制。相較化學殺蟲劑,這種策略成本低而且友善環境。此外,蚊子較不易產生抗藥性。若牠們學會避開長葉烯,代表連帶放棄花蜜,就會能量不足被迫減少繁殖。但團隊坦言,基改綠僵菌在野外能否維持活性?是否衝擊生態?實際應用前都還需審慎評估。
綠僵菌原本被動等待蚊子上門,如今在科學家巧手下獲得「散發花香」能力,搖身一變成為主動出擊的生物防治工具,可望為全球對抗病媒蚊的戰役開啟新篇章,不靠化學藥劑,而是用生態法則制衡疾病傳播。馬里蘭大學團隊於非洲與南亞展開戶外試驗,評估基改綠僵菌面對不同氣候與蚊子種類的實際效能。由於生產成本低、原料易取得,且操作簡便,有望資源有限地區推廣,幫助減少登革熱、瘧疾與茲卡等疾病的威脅。
(首圖來源:UNIVERSITY OF MARYLAND)










